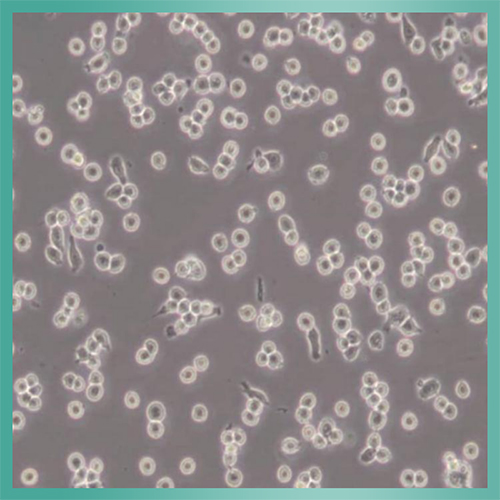
产品细节图片2

相关产品推荐更多 >
万千商家帮你免费找货
0 人在求购买到急需产品
- 详细信息
- 文献和实验
- 技术资料
- 库存:
999
- 供应商:
江西江蓝纯生物试剂有限公司
- 英文名:
Neuro-2a细胞_小鼠脑神经瘤细胞
- 规格:
T25培养瓶
Neuro2A_小鼠脑神经细胞背景描述:Neuro2A [N2a; Neuro-2a]细胞是由R·J·Klebe和F·H·Ruddle经A株白鼠的自生建立;Neuro2A [N2a; Neuro-2a]细胞产生大量微管蛋白,此蛋白在神经细胞中起应答轴浆流动的收缩系统作用。

别 称:NEURO-2A; Neuro 2a; Neuro2a; Neuro2A; N-2a; N2a; N2A; Nb2a; NB2a
种 属:小鼠
组织来源:神经母细胞
生长特性:贴壁细胞
细胞形态:神经细胞样、阿米巴样
生物安全等级:1
生长培养基:MEM(含NEAA)+10% FBS+1% P/S
推荐传代比例:1:3-1:4
推荐换液频率:2~3次/周
倍增时间:~70 hours
冻存条件:
冻存液:55% 基础培养基+40%FBS+5%DMSO
温 度:液氮
Neuro2A_小鼠脑神经细胞培养条件:
气 相:空气,95%;CO2,5%
温 度:37℃
抗原表达情况:H-2, a haploType; Mus musculus, expressed
基因表达情况:acetylcholinesterase, tubulin
保藏机构:ATCC; CCL-131 DSMZ; ACC-148 ECACC; 89121404
江蓝纯--试剂品牌由上海机纯实业有限公司和江西江蓝纯生物试剂有限公司联合打造的一个科研品牌,生产和销售高纯度特种化学品和生命科学研发用试剂产品,领域涵盖化学、分析化学、生命科学和材料科学等基础创新领域的产品,主要有精细化学试剂,电泳试剂、色谱试剂、离心分离试剂、免疫试剂、标记试剂、组织化学试剂、培养基、缓冲剂、电镜试剂、蛋白质和核酸沉淀剂、缩合剂、超滤膜、染色剂、抗氧化剂、去垢剂和表面活性剂、生化标准品试剂、生化质控品试剂、分离材料等等。
风险提示:丁香通仅作为第三方平台,为商家信息发布提供平台空间。用户咨询产品时请注意保护个人信息及财产安全,合理判断,谨慎选购商品,商家和用户对交易行为负责。对于医疗器械类产品,请先查证核实企业经营资质和医疗器械产品注册证情况。
 文献和实验
文献和实验小鼠脑神经瘤细胞概述及培养方法! 一、细胞介绍 克隆 Neuro-2A 是由 R.J.Klebe 和 F.H.Ruddle 经 A 株白鼠的自生肿瘤建立。该细胞产生大量微管蛋白,此蛋白在神经细胞中起应答轴浆流动的收缩系统作用。 二、基本信息 平台编号:bio-73109
三句话读懂一篇 CNS:注射一针即可治愈艾滋?龟类为何如此长寿,大规模研究揭开背后奥秘
,发现导致 1338 年鼠疫的菌株,起源于当地(中亚地区)! 图 2:来源 Nature 3. Nature:睡眠时循环肿瘤细胞加速扩散转移 女性乳腺癌已成为全球人数最多的癌症,虽然发病率高,但预后较好。 2022 年 6 月 22 日,苏黎世联邦理工学院(ETH)和巴塞尔大学领导的研究团队联合在 Nature 杂志发表研究论文The metastatic spread of breast cancer accelerates during sleep。 该研究在乳腺癌患者和小鼠
实验:通过 CCK-8 分析确定 TMT 在 Neuro-2a 细胞中的神经毒性。用 2μM、4μM 和 8μM TMT 处理细胞 24 小时分别导致细胞活力降低约 15%,31% 和 44%。 蛋白质组分析:确定了 8μM TMT 处理组和对照组的蛋白质表达谱。与对照组相比,TMT 组中共有 340 种差异蛋白,其中 204 种蛋白上调,136 种蛋白下调,进一步研究表明 TMT 破坏了自噬体的清除,导致它们在细胞质中的积累。IPA 显示出对 KIF5A 信号通路的抑制与自噬相关蛋白显著相关











